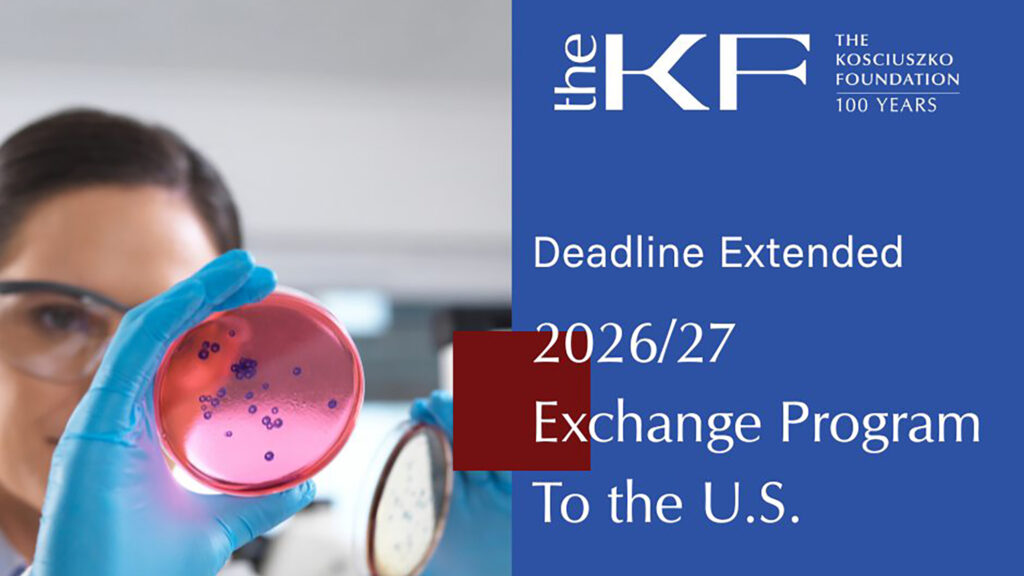
Kf exchange head

Edukacja i stypendia
Możliwości nauki i wsparcia dla młodzieży polonijnej. Poznaj dostępne programy, stypendia i szanse rozwoju.


OSHA 4 US w Nowym Jorku prowadzi kursy OSHA po polsku. Szkolenia typu BHP dla pracowników budowlanych w NY
OSHA 4 US3 gru




- Edukacja i stypendia
Application Deadline Extended for The Kosciuszko Foundation Exchange Program to the U.S.

- Edukacja i stypendia
Kościoły polskie w USA. Msze, spowiedź, komunia w NY, NJ, PA, CT, MA, AZ, FL, MD, MI
Polonijna Ksiazka15 lis
- Edukacja i stypendia
Pomoc dziecku w odniesieniu sukcesu w amerykańskiej szkole. Angielski jako drugi język – kurs ESL. Academy 4 Owls
Academy 4 Owls6 lis

- Edukacja i stypendia
Polska edukacja za granicą: Kiszyniów i online – startuje VII Międzynarodowy Dzień Edukacji Polonijnej!
Dziennik Polonijny DP 30 paź
- Edukacja i stypendia
Szkolenia dla pracujących na budowach w Nowym Jorku. Kursy OSHA w OSHKA INC
OSHA 4 US30 paź
- Edukacja i stypendia
They Teach and Bring Together Thousands of Poles Living Abroad
Family News Service28 paź
- Edukacja i stypendia
Uczą i integrują tysiące Polaków mieszkających za granicą
Family News Service27 paź